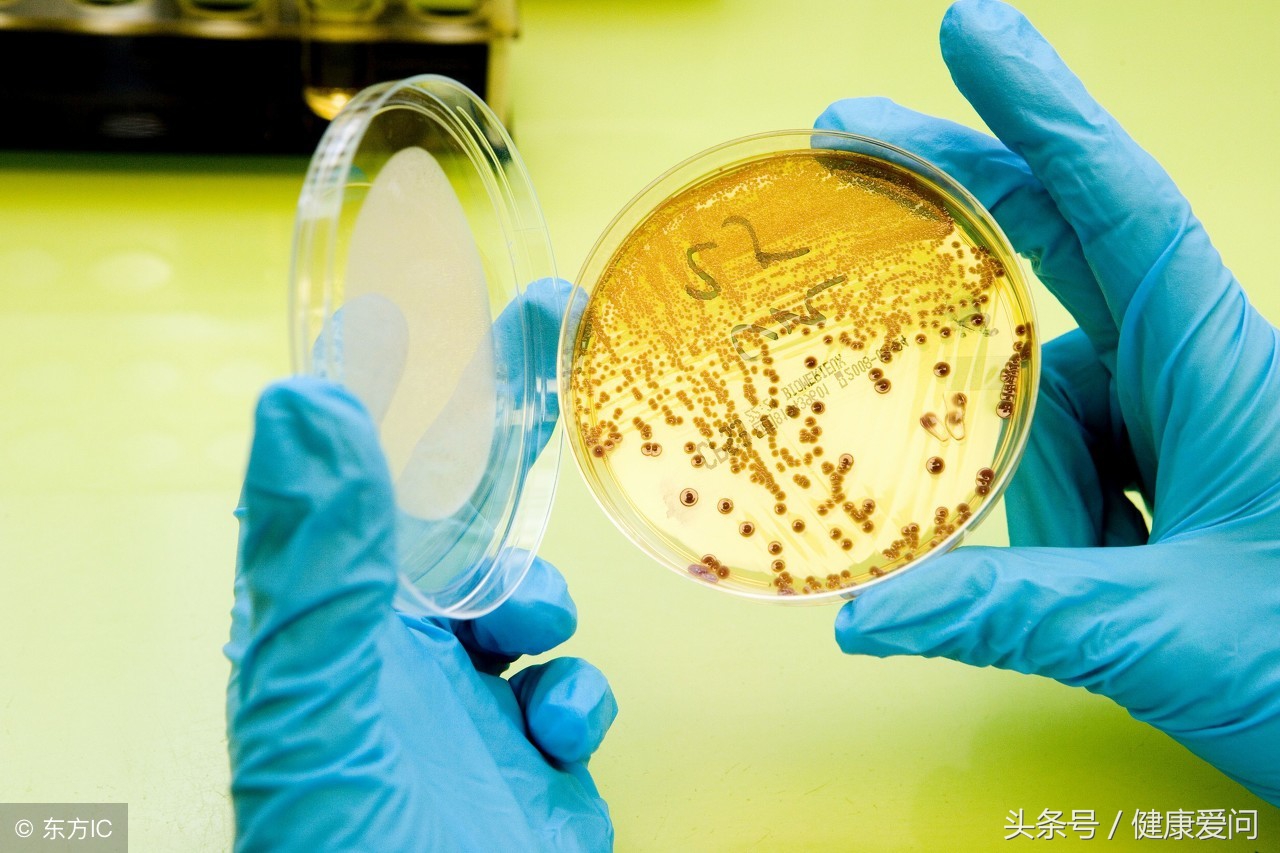
得了大肠杆菌肚子疼,大肠杆菌超标引起肚子痛怎么办

2005年,美国佛罗里达州连续发生了22起大肠杆菌感染病例,受害者几乎都是儿童。虽然这些生病的儿童分别住在三个不同的城市,却都在近期去过当地游乐场所,而且都抚摸过农场饲养的动物,如鸡,羊、牛犊等。经过检查,在个别动物身上确实发现了感染人类的大肠杆菌。从2000年起,和游乐活动相关的大肠杆菌感染时有发生,严重情况下病人还可能出现生命危险。据美国疾病预防控制中心统计,每年大约7.3万大肠杆菌感染病人中,大约有60人为此失去生命。多数大肠杆菌感染病例都与食物污染有关。从近年来连续发生的病历分析,公共卫生部门开始重视起和动物接触相关的传染途径。

大肠杆菌是什么
大肠杆菌是一种只有经过染色、在显微镜下才能看到的杆状细菌。尽管生了病才知道大肠杆菌不能小看,然而事实上,大肠杆菌中的人多数品系非但不致病,还是人类大肠中的常客。这些“良性”大肠杆菌的存在不仅能帮助人体抑制那些危害健康的细菌,还能起到分解吃进去的食物、合成对人有益的维生素的作用。相反,大肠杆菌家族里也有致病性很强的*亲近**。例如代号为O157·H7的一系,就是导致佛罗达州儿童感染的大肠杆菌。O157·H7大多生长在牛肠之中,也可以在其他家养动物的肠子里发现。这种大肠杆菌对动物不形成威胁,一旦传染给人类,就会在人体内合成、释放大量毒素。结果,给病人带来严重的肠道和整体中毒症状。
大肠杆菌感染潜伏期
O157·H7感染病人的途径是口腔。当食人的细菌达到一定数量时,O157·H7就经过胃小肠,一直混到结肠。然后,粘附在肠膜表面。O157·H7边吃边吐,吐出来的毒系最能引起局部肠膜发炎。从吃尽大肠杆菌到出现症状一般需要3~9天时间。
这段时间有被称为潜伏期。潜伏期有时可长可短。但目前认为24小时是细菌肆虐之前最短的潜伏期。

大肠杆菌感染有什么症状
O157·H7感染最典型的症状是突发性的腹部疼痛和腹泻,腹泻大部分是水样便,有人可能发展成便中带血。病人一般不发烧,有些人可能伴有呕吐。这些痢疾样症状都是因为大肠杆菌释放素毒,刺激破坏肠道黏膜造成的。患者症状轻重和每个人的抵抗力有很大关系。通常儿章和老人症状明显。大约有15%的病人其症状可能从肠道发展到血液系统,出现溶血性尿毒症。溶血性尿毒症说明潜伏着两种十分危险的并发症:肾脏功能衰竭和溶血性贫血。肾脏功能衰竭非常凶险,需要及时用人工透析的方法代替肾脏净化血液的功能。如果老年人出现溶血性尿毒症,同时伴有发烧和神经系统症状,很可能已经进展到血栓性血小板减少性紫癜。大约50%的老年病人会因此失去生命。对多数O157·H7感染的病人来说,症状会局限于水样便,病情经过大约8天的时间逐渐好转。

如何防止大肠杆菌感染
还是那句老话,“把好病从口入关”。O157·H7寄生在动物肠道内。要想将它拒之门外,必须留心粪便污染的任何媒介,包括动物本身。原来,带有O157·H7的粪便污染动物的生活坏境,也污染动物身体裁而。反复抚摸这些动物自然就把细菌沾在了于上。儿童多有吃手指头的对惯,成人吃汉堡包的时候也往往过于珍惜粘在手上的酱料。这就给细菌入口创造了方便。从美国佛罗里达州游乐场所感染得到教训是,摸了动物之后一定要洗手。为此,所有游乐场都增添了洗手设施。用肥皂,特别是杀菌肥皂认真洗手是举手之劳,却可以消除细菌。
有人问,为什么供游人抚摸的动物没有经过体检? 事实上,体检是必不可少的,问题出任体检项目上。那些和公众接触的农场动物一个个生猛活泼,健康正常。由于大肠杆菌的致病品系O157·H7对动物无害,自然不能从检查动物的一般健康状态来排除致病菌的存在与否。受污染的动物也就轻松过了关。

尽管O157·H7感染的病例多与动物有关,最初引起医学界关注的,却是从美国一家叫做“盒子里的杰克”的快餐连锁店开始。1993年1月,几百名食客因为吃了污染的汉堡包发病。其中4名儿童终因不治丧生。从此,严做O157·H7大肠杆菌检验使这家快餐店成了美国快餐行业中的卫生模范。牛肉表面沾染的致病菌很可能是在屠宰过程中受到污染。受到O157·H7污染的生肉既不会变色也不会变味只有通过加热才能彻底杀灭。因为汉堡包用的肉饼用肉馅做成,在绞馅过程中,O157·H7从生肉表面混进馅饼深部。如果加热时肉饼深部温度不够高,就不能达到彻底灭菌的目的。


此外,防止病从口入还包括养成良好的卫生习惯。在厨房遵守“生熟分开”的原则。清洗接触生食的物品;外出时注意饮食卫生;游泳时避免喝水。督促肠炎病人随时消毒,不要到公共场所游泳。当然,也包括和动物保持一定距离。